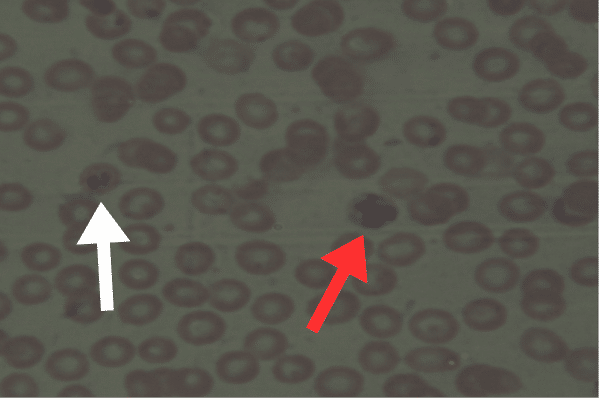
Malaria Case Study Image Figure 1. White arrow ring form and red arrow Schizont form

Clinical Laboratory Visibility as an Educator
Volume 39 Number 2 | April 2025 Sarah Bergbower, DCLS, MLS(ASCP)CM, ASCLS Today Volunteer Contributor I now realize that as an educator, I am in a unique position. I do not teach in a clinical laboratory sciences program, nor am I associated with such a program in any way. I therefore heavily debated whether attending…